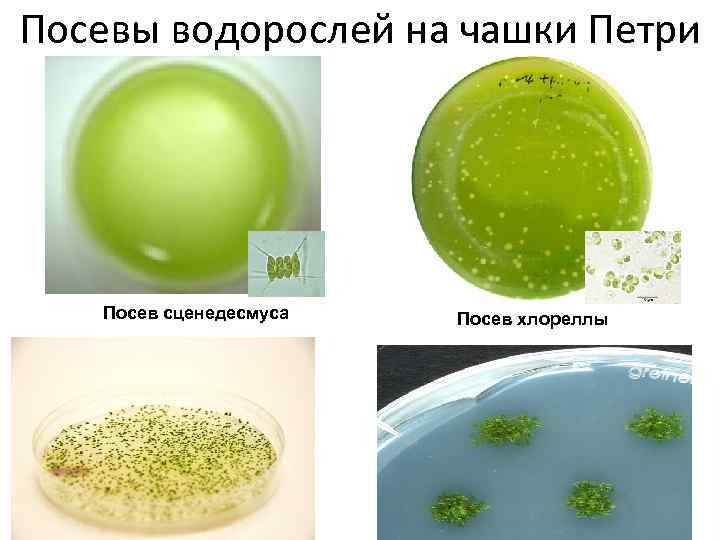
Посевы водорослей на чашки Петри Посев сценедесмуса Посев хлореллы

Курс водорослей2013.pptx
- Количество слайдов: 33

Монадный Амебоидный Нитчатый Пальмеллоидный Коккоидный

Сифоновый Органоподобный Пластинчатый Колониальный


Характеристика сине-зеленых водорослей. Надцарство Доядерные – Procaryota Царство Дробянки – Mychota Подцарство Цианобионты – Cyanobionta Отдел Сине-зеленые водоросли – Cyanophyta Класс Хроококовые – Chroococcophyceae Класс Горомогониевые - Hormogoniophyceae Таллом одноклеточный или колониальный, коккоидной или нитчатой структуры, микроскопический. Пигменты хлорофилл, синий фикоциан и красный фикоэритрин Запасающие вещества гликоген, белок цианофицин, фосфолипид волютин Размножение только вегетативное, делением клеток, разрывом таллома, а у нитчатых также специфическим способом – с образованием гормогоний. Движение Пассивно плавающие, некоторые нитчатые водоросли обладают способностью к медленному самостоятельному змееподобному движению

Microcystis ласс Chroococous Oscillatoria Anabaena Spirulina

Цветение Днепра

Замор рыбы, вызванный массовым цветением сине-зеленых водорослей

Характеристика жгутиковых водорослей. Надцарство Ядерные – Eucaryota; Царство Растения – Plantae; Подцарство Настоящие водоросли – Phycobionta; Отдел Эвгленовые водоросли – Euglenophyta; Отдел Пирофитовые водоросли – Pirrophyta; Отдел Хризофитовые (Золотистые водоросли) – Chrysophyta Отдел Эвгленовые водоросли – Euglenophyta Таллом одноклеточные, реже колониальные формы, имеющие, как правило, один жгутик, у основания жгутика – стигма Пигменты Запасающие вещества Размножение хлорофилл, каротин, ксантофилл углевод парамилон Размножение в подавляющем большинстве случаев – вегетативное, делением клеток вдоль Движение При помощи жгутика

Euglena Trachelomonas

Отдел Пиррофитовые водоросли (Pyrrophyta) Таллом одноклеточные двужгутиковые формы. Клетка находится внутри твердого прозрачного целлюлозного панциря, состоящего из отдельных щитков, округлого или с выростами (рогами). Пигменты хлорофилл и очень большая и разнообразная группа бурых ксантинов Запасающие вещества крахмал и масла Размножение в основном вегетативное, делением клетки, реже бесполое с помощью двужгутиковых зооспор Движение На панцире две бороздки – продольная и поперечная, в которых располагаются жгутики: один из них работающий, второй – пассивный

Ceratium

Отдел Хризофитовые или Золотистые водоросли (Chrysophyta) Таллом Пигменты Запасающие вещества Размножение Движение Колониальные (пальмеллоидные или нитчатые), значительно реже одноклеточные одно- или двужгутиковые формы. Оболочки клеток пектиново-целлюлозные, иногда пропитаны кремнеземом (Si. O 2) хлорофилл, каротин, ксантофилл и желто-бурые ксантины, среди которых преобладает ярко-желтый лютеин, придающий таллому золотистую окраску углевод, лейкозин и масла делением клеток (вегетативное), бесполое с помощью зооспор. Имеются сообщения о половом размножении посредством изо-, гетеро- и хологамии При помощи жгутика

Synura Dinobryon

Отдел Диатомовые водоросли (Bacillariophyta) Таллом представлен микроскопическими одноклеточными или колониальными формами коккоидной структуры Пигменты зеленый цвет хлорофилла резко подавляется желтыми и бурыми пигментами ксантофиллом, фукоксантином Запасающие вещества масло, волютин, лейкозин Размножение Вегетативное деление по бороздке между эпитекой (большей створки) и гипотекой (меньшей створки), с дальнейшим построением недостающей створки. При измельчении переходит к половому размножению с образованием ауксоспор. Движение при помощи жгутиков

Cymbella Diatoma Asterionella

Cyclotella Melosira

Характеристика зеленых водорослей. Надцарство Eucaryota Царство Plantae Подцарство Phycobionta Отдел Chlorophyta Таллом Все виды талломов Пигменты хлорофилл, каротин и ксантофилл Запасающие вещества крахмал Размножение Различное: бесполое Движение Различное: свободноплавающие, помощи жгутиков, прикрепленные, вегетативное, половое, при

Chlamydomonas Volvox Eudorina

Chlorella Pediastrum Scenedesmus Hydrodictyon

Ulothrix Ulva

Cladophora

Spirogyra Zygnema

Closterium Cosmarium

Отдел Харовые водоросли (Charophyta) Надцарство Eucaryota Царство Plantae Подцарство Phycobionta Отдел Charophyta Таллом органоподобный Пигменты Хлорофилл Запасающие вещества Крахмал Размножение Вегетативное (клубеньками, частями таллома), половое – оогамия, с преобладанием гаплоидной фазы Движение прикрепленные

Chara

Отдел Желто-зеленые водоросли (Xanthophyta) Надцарство Eucaryota Царство Plantae Подцарство Phycobionta Отдел Xanthophyta Таллом морфо-анатомическая Пигменты преобладает зеленый хлорофилл (как у зеленых водорослей), с другой стороны – высокое содержание, примерно равным содержанию хлорофилла, желтых пигментов (каротин, ксантины) Запасающие вещества крахмал, масла, лейкозина Размножение Вегетативное (клубеньками, частями таллома), половое – оогамия, с преобладанием гаплоидной фазы Движение прикрепленные

Vaucheria

Отдел Бурые водоросли (Phaеophyta) Надцарство Eucaryota Царство Plantae Подцарство Phycobionta Отдел Phaeophyta Таллом Пигменты Многоклеточный макроскопический органоподобный (нитчатый или пластинчатый) Бурые ксантины, фукоциан, хлорофилл Запасающие вещества ламинарин, маннит, масла Размножение Вегетативное размножение осуществляется разрывом таллома, бесполое – разножгутиковыми зооспорами или значительно реже неподвижными апланоспорами. Последние формируются в спорангиях либо по одной и тогда называются моноспорами, либо по четыре – тетраспоры, в большем количестве – полиспоры. Половое размножение происходит по типу изо-, гетеро- или оогамии. прикрепленные Движение

Ectocarpus Fucus Laminaria

Отдел Красные водоросли или Багрянки (Rhodophyta). Надцарство Ядерные (Eucaryota) Царство Растения (Plantae) Подцарство Настоящие водоросли (Phycobionta) Отдел Красные водоросли (Rhodophyta) Таллом начиная от одноклеточных и колониальных до многоклеточных форм с нитчатой и пластинчатой органоподобной структурой. Клетки одно- или многоядерные с целлюлозно-пектиновой сильно ослизняющейся оболочкой. Пигменты хлорофилл, каротин, ксантофилл, а также синий фикоциан и красный фикоэритрин. Запасающие вещества багрянковый крахмал и дисахариды, в т. ч. сахароза. Размножение Вегетативное размножение имеется только у простейших одноклеточных форм – делением клетки. Бесполое – с помощью моно-, тетра- или полиспор. В результате полового размножения формируются споры полового размножения – карпоспоры. Тип полового размножения – оогамия. Движение прикрепленные в небольших количествах

Batrachospermum Porphyra
Посевы водорослей на чашки Петри Посев сценедесмуса Посев хлореллы

Курс водорослей2013.pptx